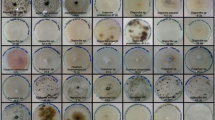

Abstract
This study aimed at the exploitation of lignocellulosic wastes for the evaluation of the newly isolated white-rot fungal strains enzymatic potential for bioethanol production. The isolates belonging to Basidiomycetes, Fomes fomentarius TMF2, Schizophyllum commune TMF3, and Bjerkandera adusta TMF1, could synthesize extracellular laccase and various hydrolase while growing on lignocellulosic waste materials. More specifically, for the first time, F. fomentarius TMF2 synthesized laccase using sunflower meal as a substrate. This substrate could stimulate B. adusta TMF1 for carboxymethyl cellulase and Avicelase production. The isolate B. adusta TMF1 was able to produce amylase during its growth on brewerʼs spent grain, which is up to now the best result reported for this activity of any B. adusta strain. Soybean meal was the most potent substrate for stimulating pectinase production by B. adusta TMF1 and S. commune TMF3. While growing on brewerʼs spent grain, B. adusta TMF1 and S. commune TMF3 produced high levels of xylanase. Spent coffee residues were for the first time tested as a substrate for hydrolase production by selected fungal species. Also, this is the first attempt where the produced enzymes by isolate B. adusta TMF1 were used for lignocellulose hydrolysis of brewerʼs spent grain and corn stover for bioethanol production, where under non-optimized conditions 0.94 g/L and 0.86 g/L of bioethanol could be produced, respectively. This study showed that novel white-rot fungal isolates, especially B. adusta TMF1, could grow on unexploited, low-cost lignocellulosic substrates and to produce biotechnological value-added products within environmental and economical accepted processes.
Graphical abstract

Similar content being viewed by others
Explore related subjects
Discover the latest articles, news and stories from top researchers in related subjects.Avoid common mistakes on your manuscript.
1 Introduction
Fungal diversity in the natural environment is enormous. Fungi are widely distributed in almost all ecosystems, while Basidiomycetes, a phylum within the fungal kingdom, have an essential role in ecosystem balance.
Basidiomycetes are the major decomposers of plant biomass and are also called wood-decaying fungi. These fungi can utilize different natural carbon sources because of their various plant-polysaccharide-degrading capabilities [1, 2]. In particular, Basidiomycetes from the white-rot fungi (WRF) group are among the most efficient extracellular hydrolytic and oxidative enzyme producers [3,4,5]. Their hydrolytic system mainly consists of cellulases and xylanases, while the oxidative-ligninolytic system is composed of laccases, ligninases, and peroxidase, which degrade lignin and phenyl components. This is of fundamental importance for the hydrolysis of the recalcitrant lignocellulosic biomass to simple sugars and further biotechnological applications [6, 7].
Lignocellulose, which consists of cellulose, hemicellulose, and lignin, is the major renewable source of organic matter in the world. There are different agricultural types of waste with predominant lignocellulose components including brewer’s spent grain (BSG), the main by-product of the brewing industry. BSG contains mostly arabinoxylan, lignin (12–21%), and cellulose [8, 9], while starch content varies, depending on the mashing efficiency [10]. Sunflower meal (SFM) has a high content of raw fiber, lignin (9–12%), phenols, and proteins [11]. Soybean meal (SBM) is rich in proteins, pectin, and lignin (1–4%), while spent coffee residues (SCR) have a high cellulose content (8.6%) but very low levels of the pectin (only 0.01%) and lignin (0.05%) [12]. Although some of the mentioned waste materials can be exploited as raw materials or find direct application, such as SBM, which is used as feed, when accumulated in large quantities, agricultural wastes cause environmental and pollution problems [13, 14]. To overcome these problems, following the principles of the circular economy, the effective exploitation of these waste materials by their reuse for the production of biotechnologically added value products is highly desirable.
It is well known that many fungi and bacteria are capable of degrading lignocellulosic biomass in a different manner and extent [15, 16]. Also, many various commercial enzymatic preparations for this purpose already exist on the market. Nevertheless, there is a constant need for screening the new strains, particularly fungi, that are suitable for developing the more efficient enzyme cocktails for complete and enhanced lignocellulose hydrolysis [17]. The constant need for screening the new isolates can be explained by enormous morphological, physiological, and ecological fungal diversity and consequently the incompletely examined enzymatic potential of many fungal species. Moreover, every description of fungal species presents the big challenge because each fungus is unique with its characteristics and enzymatic potential [18]. In addition, the existing fungal species have already been extensively tested and their enzyme potential has been exploited in line with circular economy [18].
The utilization of lignocellulose waste materials is often based on WRF, which, owing to their unique and potent enzymatic system gained the great interest for application in biotechnology, in various industrial processes, especially in bio-refinery for biofuels production [19, 20]. The usage of thus obtained biofuels, especially bioethanol, is of enormous importance for the environment since bioethanol is a renewable and environmentally favorable alternative for fossil fuels that can cause pollution and global warming [21]. Moreover, the consumption of bioethanol enables overcoming the energy crisis due to the reduction of non-renewable energy sources [22].
Thus, the aim of this study was to explore the enzymatic potential of three newly isolated white-rot fungi during the growth on four different and abundant agricultural waste materials and to evaluate the most suitable substrate and basidiomycete for the production of different classes of extracellular enzymes. In addition, for the first time, the produced crude enzyme cocktail by the selected isolate (according to the obtained results) will be used in the hydrolysis process of the lignocellulose biomass and further for bioethanol production.
2 Material and methods
2.1 Chemicals and sample materials
Carboxymethyl cellulose (CMC), pectin, and xylan were purchased from Sigma-Aldrich, while soluble starch and microcrystalline cellulose (Avicel) were purchased from Merck. The malt extract broth was purchased from Torlak, Serbia. Guaiacol was purchased from Fisher Scientific Acro. Other chemicals were the highest commercial grades purchased from Merck and Lach-Ner. SFM and SBM were kindly donated from a local factory Bioprotein, Serbia, while BSG was donated by the local brewery from Serbia. The SCR were collected from the local café. The corn stover was kindly donated by local agricultural cooperative “Mrkšićevi salaši,” Srpski Itebej, Serbia.
2.2 Isolation of fungal strains
White-rot fungi were collected from the deciduous forest of mountain Avala, Serbia, from a beech (Fagus sylvatica) tree. Fruiting bodies were sterilized in 70% ethanol and inner parts were cut into pieces (3–5 mm) and transferred onto fresh malt extract agar (MEA) plates (malt extract 17 g/L and agar 15 g/L). Incubation was carried out at 30 °C in the dark. After a few days, mycelium growth has occurred. Small pieces (1 × 1 cm) of mycelium were cut from the agar plate and transferred onto a fresh MEA plate until the pure culture was obtained. The pure mycelium culture was stored at + 4 °C on MEA plates.
2.3 Molecular identification of fungal isolates
DNA extraction and PCR amplification were carried out according to the procedure described by Jović and coworkers with some modifications. Genomic DNA was extracted from 4-day-old fungal cultures grown in liquid medium using the established cetyl trimethyl ammonium bromide (CTAB) method [23, 24]. Briefly, cell walls of fungal mycelia were broken down by grinding with glass rods. The CTAB extraction buffer that contained β-mercaptoethanol was then added in the samples and after three consecutive of freezing (− 20 °C) and thawing (65 °C) purification with chloroform and precipitation with isopropanol were performed. Finally, the DNA was dissolved in 50 µL ultrapure water. For PCR amplification of the internal transcribed spacer (ITS) region of the ribosomal RNA coding DNA, a primer set ITS1/ITS4 was used. The extracted total DNA served as a template. The 50-µL reaction mixture contained 1 µL of DNA template, 1 µL 10 µmol/L forward primer (ITS1: 5’-TCCGTAGGTGAACCTGCGG-3’), 1 µL 10 µmol/L reverse primer (ITS4: 5’-TCCTCCGCTTATTGATATGC-3’), 25 µL 2 × PCR LongNova-RED Master Mix (DNA GDAŃSK, Blirt S.A., Gdańsk, Poland), and 22 µL ultrapure distilled water. The PCR amplification was performed in QB24 Thermal Cycler (Quanta Biotech Ltd., Byfleet, UK). The temperature parameters were set as follows: 15 min at 95 °C for initial denaturation, 30 cycles of denaturation step (30 s at 95 °C), annealing step (30 s at 55 °C), and elongation step (90 s at 72 °C) and 5 min at 72 °C for final extension [24, 25].
Amplified PCR products were double side sequenced by Macrogen, quality checked, and aligned. The resulting sequences representing the partial sequence of ITS region of approximately 500 bp in length were deposited in the NCBI GenBank database.
2.4 API ZYM test for determination of enzymatic extracellular activities
For the API ZYM test, the fungal mycelia were grown on MEA plates. After 4 days of incubation (30 °C), a mycelium from agar plates was used to prepare a suspension in a saline solution. Four pieces of mycelium of each culture were placed in 1 mL of sterile saline solution and homogenized until uniform mycelia suspension was obtained. Biochemical tests were performed using the API ZYM kit (bioMérieux, USA) according to the manufacturer’s instructions.
The incubation of the strips was performed at 30 °C. The color readings were performed using the API ZYM color scale, supplied by the manufacturer ranging from 0 (negative) to 5(maximum).
2.5 Inoculum preparation
The inoculum was prepared by growing the mycelia on MEA plates. MEA, used for inoculum preparation, composed of malt extract broth (20 g/L) and agar (15 g/L), was previously sterilized and poured into Petri dishes (Petri dishes 90 mm in diameter). Mycelia discs (2 × 2 cm) were cut out of the mycelia growing on MEA and aseptically transferred into the center of different agar plates which contained selective substrate for testing enzymatic activity. The plates were incubated at 30 °C, in the dark, for 4–6 days. For the inoculation of SFM, SBM, BSG, and SCR, four mycelium discs (1 × 1 cm) were cut from the same Petri dish with MEA and transferred into Erlenmeyer flasks that contained a wetted substrate.
2.6 Qualitative test for detection of enzyme activity
Selective agar medium plates (malt extract 17 g/L and agar 15 g/L) supplemented with selective substrates (1.0 g/L) were used for the detection of enzyme activities. For cellulases (CMCase and Avicelase) activity, CMC-carboxymethylcellulose and Avicel (microcrystalline cellulose) were added separately, for amylase soluble starch, for pectinase pectin from apple and for xylanase beech wood xylan were added. The plates were incubated at 30 °C in the dark for 4–6 days. After incubation, agar plates were flooded with Gram’s iodine (2.0 g KI and 1.0 g I2 in 300 mL distilled water) for 5 min. Clear zones around mycelium indicated enzyme activity [26].
For the determination of laccase production, 0.05% guaiacol was added to the malt extract broth with 1.5% agar–agar. The plates were incubated in dark at 30 °C for 2–4 days. The presence of dark/brown color under and/or around mycelia was considered a positive result for guaiacol oxidation and laccase production.
2.7 Solid-state fermentation and enzymes production
For solid-state fermentation, SFM, SBM, BSG, and SCR were used as waste substrates for mycelium growth and enzyme production. The substrates were wetted to obtain final moisture content of 70% and each substrate was weighed and placed in 300-mL Erlenmeyer flasks. After autoclaving (121 °C, 20 min) and cooling, the flasks were inoculated with mycelium (four mycelium discs (1 × 1 cm) of approx. 15% of the inoculum). Incubation was carried out at 30 °C in a dark for 6 days. Extraction of enzymes was performed in a rotary shaker (190 rpm, 30 min, 25 °C) by mixing the fermented media with 50 mL of 0.1 M acetate buffer pH 5.0. After centrifugation (6000 rpm, 15 min, 4 °C), the obtained supernatant was used as a crude enzyme extract and was further analyzed for laccase, amylase, pectinase, xylanase, and cellulase (CMCase and Avicelase) activities.
2.8 Quantitative test for enzyme activity
The determination of laccase activity was based on the oxidation of guaiacol. This assay was performed according to the procedure described by Jović and coworkers [24].
Cellulase (CMCase and Avicelase), amylase, xylanase, and pectinase activities were measured by a reduction of 3,5-dinitrosalicylic acid in the presence of reducing sugar released by enzymatic hydrolysis of cellulose, starch, xylose, and pectin, respectively, according to the method of Miller [27]. The calculations were performed based on the standard curves prepared using appropriate reducing sugar (glucose, xylose) and d-galacturonic acid. The assays for hydrolytic enzyme activity determination were performed as described earlier [28].
Enzyme activity (E.A., IU/g) of solid substrate for each enzyme was calculated according to the equation:
where E.A. is enzyme activity (U/mL), V is buffer volume used for enzyme extraction (mL) and ms is a mass of solid substrate (g).
2.9 Enzymatic hydrolysis and bioethanol production
The crude enzyme cocktail of the most potent isolate, selected with accordance to the previously obtained results, was used for the hydrolysis process of the lignocellulose substrate in order to evaluate the bioethanol production potential. Hydrolysis was performed in Erlenmeyer flasks (100 mL) using 5% (w/v) of a lignocellulosic waste substrate (previously autoclaved 121 °C, 1.2 bar, 20 min) at 50 °C for 72 h in a rotary shaker (130 rpm). After the hydrolysis, the reaction mixture was centrifuged (6000 rpm, 10 min) and clear supernatant was used for the detection of reducing sugars. The concentration of total reducing sugars was determined by DNS method in aliquots before and after hydrolysis as equivalent to previously determined glucose concentration [27]. The obtained hydrolysate was used for bioethanol production by waste brewer’s yeast Saccharomyces cerevisiae [20]. For yeast fermentation, 3% of the yeast inoculum was used. The brewer’s yeast was previously grown in malt extract broth (24 h, at 30 °C). The fermentation was carried out for 48 h at 30 °C.
The ethanol concentration was determined based on the density of alcohol distillate at 20 °C and expressed in weight percent (w/w) [28].
The ethanol yields were calculated according to these equations:
where YE is ethanol yield per sugar consumed (g/g);
where ɳ (%) is fermentation efficiency calculated on theoretical ethanol value;
2.10 Statistical analysis
The results of enzyme activities are mean values of three replicates ± standard errors. The means were compared by analysis of variance (ANOVA). One-way ANOVA followed by Tukey test was applied to evaluate the effect of each substrate for the particular enzyme production by specified WRF. Differences were considered significant at p < 0.05. Data analysis was performed using OriginPro 8.5.
3 Results and discussion
3.1 Identification of isolated white-rot fungi
WRF were preliminary identified based on morphological characteristics. Regarding morphological characteristics, F. fomentarius TMF2 formed wooly white cottony colonies with light creamy brown colonies on the MEA. B. adusta TMF1 formed white loose cottony aerial mycelium that was made of white fast-growing colonies. S. commune TMF3 formed wooly white mycelium spread over the entire substrate.
All tested white-rot fungal isolates belonged to the Basidiomycetes phylum. The WRF strains, designed as Fomes fomentarius TMF2, Bjerkandera adusta TMF1, and Schizophyllum commune TMF3, were identified as Fomes fomentarius, Bjerkandera adusta, and Schizophyllum commune based on a sequence that includes the internal transcribed spacer region (ITS) sequence, located between the 18S and 5.8S rRNA and 5.8 rRNA coding genes. This region is widely used for analyzing fungal diversity in environmental samples [29]. The obtained sequences were deposited in the NCBI-GenBank database under the following accession numbers: MW327505 for B. adusta, MW327506 for S. commune, and MW327504 for F. fomentarius. The species identification based on the sequence was performed by using nucleotide BLAST search as integrated on the NCBI webpage, and by using nucleotide collection database. All species were identified based on high (over 99.5%) sequence similarity with only one species from the database.
3.2 Detection of enzyme activities using the API ZYM
The examination of the hydrolytic enzyme activities of all tested isolates was done using the API ZYM test (Table 1). This test is simple, rapid, and reliable and is widely used for identifying various hydrolytic enzymes present in novel strains [30].
All tested WRF showed a broad range of extracellular enzyme activities. Beta glucosidase activity was very high for these isolates, indicating that these fungi have a good potential for cellulose degradation [31]. Acid phosphatase was negative for F. fomentarius TMF2 and S. commune TMF3 but strong for B. adusta TMF1. F. fomentarius TMF2 and S. commune TMF3 produced α- and β-galactosidase and mannosidase, suggesting potential for enzymatic hydrolysis of different carbohydrates. Esterase C4, esterase lipase C8, leucinearylamidase, and valinearylamidase were present at medium levels at B. adusta TMF1 while cystinearylamidase was found at a low level at F. fomentarius TMF2 and B. adusta TMF1.
Very high levels of lipase C 14 were detected in F. fomentarius TMF2 and S. commune TMF3.
The API ZYM test confirmed that the enzymatic system of the isolated WRF is diverse.
3.3 Detection of enzyme activity using a qualitative test for hydrolases and laccase
F. fomentarius TMF2, B. adusta TMF1, and S. commune TMF3 were able to grow on CMC, Avicel, pectin, starch, xylan, and guaiacol agar plates. For F. fomentarius TMF2 and S. commune TMF3, extracellular hydrolytic enzyme activities were observed already after 2 days of mycelium growth, while for B. adusta TMF1 strain was noticed after 4–5 days of incubation.
The occurrence of a halo zone around the mycelium indicated the area of the substrate hydrolysis and thus the presence of the specific enzyme (Fig. 1). These strains were able to utilize both types of cellulose, CMC as a soluble form of cellulose and Avicel as microcrystalline cellulose, because of their synergistic endoglucanase and exoglucanase systems, which is typical for WRF [32]. F. fomentarius TMF2 and B. adusta TMF1 mycelia were very dense and within the mycelium growth was the inner clearance zone that indicated amylase, pectinase, and xylanase activity. A similar zone of clearance for Fomes sp. was reported by Hadda and coworkers [32]. The very dense mycelium of B. adusta TMF1 on starch, pectin, and xylan substrates made it impossible to identify the zone of clearance (Fig. 1), but after removing the mycelium, the amylase, pectinase, and xylanase activities could be detected as a very clear zone through the entire growth surface (Fig. 1).
Laccase activity was noticed after 24 h of mycelium incubation for F. fomentarius TMF2 and B. adusta TMF1 and after 48 h of incubation for S. commune TMF3 using guaiacol as an oxidizing reagent. The brown color under the mycelia indicated the presence of laccase (Fig. 1).
3.4 Solid-state fermentation and enzymes production
In solid-state fermentation (SSF), the most important step is the selection of appropriate lignocellulosic substrate for WRF growth and enzyme synthesis [3]. Literature data showed that various lignocellulosic waste substrates, such as sugarcane bagasse, wheat straw, wheat bran, or corn stover could be applied for the enzyme production by WRF [13, 33,34,35]. Among them, wheat bran is the most used substrate for WRF enzyme induction. For example, wheat bran was used for cellulase, xylanase, and laccase production by Fomes sp. [36, 37], and for cellulase production by S. commune [38], while wheat straw was used for cellulase synthesis by B. adusta [39].
The literature data about the simultaneous production of laccase and hydrolytic enzymes on BSG, SCR, SFM, and SBM by WRF is still very scarce. In this study, the production of cellulases (CMCase and Avicelase), amylase, pectinase, xylanase, and laccase by three tested isolates on these lignocellulosic waste substrates was evaluated. The results showed that all used substrates could support WRF growth and enzyme synthesis. However, some differences were observed in terms of the suitability of the substrates to stimulate the synthesis of specific enzymes by each WRF tested (Tables 2, 3, 4).
For F. fomentarius TMF2, SFM seemed to be the most potent lignocellulosic waste substrate for induction of both laccase and hydrolase production (Table 2). This substrate is usually used for microbial amylase production by the genus Bacillus [40], but it was also used as a substrate for the simultaneous production of various hydrolases (cellulases (CMCase and Avicelase), amylase, pectinase, and xylanase) by actinomycetes Streptomyces fulvissimus CKS7 isolated in our group [28]. Thermophilic fungus Humicola lanuginosa was used for cellulase production during SSF of SFM [41]. It has not been shown until this study that a strain of F. fomentarius could grow on sunflower meal and synthesize extracellular laccase. Compared with Trametes versicolor laccase, produced in submerged fermentation using 2% (w/v) sunflower stems [42], higher laccase activity was reported in our study (35 IU/L vs. 2.45 IU/g). Slightly lower F. fomentarius TMF2 laccase activity was obtained on BSG (2.28 IU/g), while activities on SBM and SCR were significantly lower.
F. fomentarius TMF2 showed also the highest amylase activity (27.29 IU/g) on SFM, compared to other tested substrates. Pectinase and xylanase produced by F. fomentarius TMF2 on SFM reached activity of 10.86 IU/g and 16.84 IU/g, respectively, and these values were also the highest among all tested substrates. However, these values were not significantly higher than the pectinase activity on SBM (9.34 IU/g) and xylanase activity obtained on BSG (15.88 IU/g), suggesting these three substrates were suitable for pectinase and xylanase production by F. fomentarius TMF2.
Spent coffee waste, as lignocellulosic material, induced a very low enzyme activity, especially for laccase and pectinase (0.21 IU/g and 1.02 IU/g, respectively). However, SCR showed to be a suitable substrate for CMCase production by F. fomentarius TMF2 with 1.32 IU/g, which was not significantly lower than values obtained on SFM and BSG (1.42 IU/g and 1.49 IU/g, respectively). Keeping in mind its composition, these results were expected.
Literature data showed that coffee pulp, coffee husk, and spent coffee grounds were mainly used as substrates for WRF growth [9, 43]. The different chemical composition of these coffee by-products affects the fungal growth and the absorption of nutrients necessary for enzyme synthesis [12]. The most studied WRF, with the potential to grow on different coffee waste substrates, belong to genus Pleurotus [43]. However, there is a lack of literature data about Basidiomycetes growth on coffee waste substrates.
B. adusta TMF1 and S. commune TMF3 showed a similar pattern of response to substrates used for stimulation of different enzyme synthesis (Tables 3 and 4). The laccase activities of 1.44 IU/g and 2.79 IU/g produced by B. adusta TMF1 and S. commune TMF3, respectively, obtained on BSG as a substrate were significantly higher than laccase activities on other waste substrates. The literature data generally reports lower laccase activities produced by these WRF species. For example, testing the ligninolytic potential of B. adusta under different growth conditions, Tripathi and coworkers [44] found laccase activity of 64 U/L only in nutrient-rich medium, after 20 days of growth under static conditions. These authors suggested that laccase activity was inducible in this WRF. There are studies that reported no laccase activity in B. adusta [45, 46].
Pariatamby and Nithiya [47] reported laccase activity ~ 1.0 IU/g for S. commune after 7 days of growth on BSG. In the study of Zhu and coworkers, no laccase activity was detected for S. commune during 30-day SSF on Jerusalem artichoke stalk [17]. However, literature data also reported higher values of laccase activity under optimized conditions [48].
The most suitable substrate for amylase production by B. adusta TMF1 and S. commune TMF3 was BSG with measured activities of 11.47 IU/g and 10.98 IU/g, respectively. Moderate amylase activities were obtained on SFM and SBM, while SCR was the least appropriate substrate for inducing amylase production. It is interesting to note that the enzymatic potential of B. adusta was mainly associated with the decomposition of lignocellulose biomass, while in this study we showed, for the first time, that amylases produced by this species could degrade starch to simple sugars. Shimazaki and coworkers [49] reported amylase activities after 9 days of cultivation S. commune under shaking conditions from 0.69 to 30.0 IU/mL, depending on the carbon source. The highest activity was obtained with 5% wheat bran as a carbon source and it was higher than the highest activity obtained in our study (30.0 IU/mL vs. 10.98 IU/g). Starch content in wheat bran varies from 9 to 26% [50] and this is higher content than present in all different substrates used in our study. Therefore, even higher amylase activities produced by S. commune TMF3 could be expected after cultivation on a richer substrate.
The most suitable substrate for pectinase production by B. adusta TMF1 and S. commune TMF3 was SBM (Tables 3 and 4). This could be expected given that the pectin content in SBM is higher than in the other tested substrates [51].
Ganbarov and coworkers [52] studied pectinase production of five fungi belonging to the genus Bjerkandera on wheat bran during SSF. Two of these five fungi (B. adusta 41 and B. fumosa 97) had a lower pectinase activity, than pectinase activity obtained in our study (22.1 IU/g and 10.3 vs. 23.73 IU/g), while higher pectinase activities were reported at B. adusta 1 (25.4 IU/g), B. adusta 40 (54.1 IU/g), and B. fumosa 22 (44.7 IU/g) strains.
Within this study, 9.25 IU/g for pectinase activity of S. commune TMF3 was noted on the SBM. Mehmood et al. [53] reported a higher value of produced pectinase (480.45 IU/g) than in our study, by growing S. commune on optimized solid medium citrus waste— mosambi peels (sweet limetta). Interestingly, during SSF on Jerusalem artichoke stalk, pectinase activity for S. commune was not detectable [17]. It is important to note that enzyme activity in our study was determined only after 6 days of growth and no optimization has been performed, and that could contribute to their relatively low observed pectinase activity.
The highest levels of xylanase activities of 18.39 IU/g and 17.47 IU/g produced by B. adusta TMF1 and S. commune TMF3, respectively, were measured on BSG as substrate (Tables 3 and 4). A high level of xylanase activity by S. commune was also reported in the work of Gautam and coworkers [54]. Another study showed that S. commune could produce xylanase in submerged fermentation, while growing on bamboo, sugarcane bagasse, and banana stem, for 15 days. The obtained xylanase activity was very low on bamboo and banana stem, while on sugarcane bagasse this activity reached the value of ~ 1.2 IU/mL.
A literature survey showed that studies about Bjerkandera sp. xylanase production on waste substrates are extremely scarce. Only Qirouz-Castaneda and coworkers [28] reported xylanase production by this WRF on several waste substrates with maximum xylanase-specific activity of 0.4 IU/mg of proteins obtained using oak dust for B. adusta growth.
S. commune TMF3 and B. adusta TMF1 produced a maximum of cellulase activity (2.51 IU/g and 3.71 IU/g respectively) during the growth on SFM. Literature data about cellulase production by S. commune during SSF are very rare with exception of the work of Zhu and coworkers [17]. In their study, S. commune was grown on a Jerusalem artichoke stalk (mixed with Mandels’ salt solution) during 30 days and produced cellulases. Maximum of endoglucanase activity, 15.2 IU/g, was reached after 20 days of incubation. In the study of Qirouz-Castaneda [28], B. adusta was grown on a solid agar plate with 2% wheat straw and produced maximum CMCase activity of 2.4 IU/mg proteins. It is important to note that all of these results are difficult to compare due to the different methods for fungal growth and due to the different reported expressions of cellulase activities.
3.5 Enzymatic hydrolysis
Based on the results obtained within this study, the novel isolated strain B. adusta TMF1 was selected as the optimal (with regard to the possessing enzymatic potential) for evaluating the bioethanol production potential. Thus, the crude enzyme cocktail produced by the B. adusta TMF1 was used for the hydrolysis of two lignocellulosic substrates, BSG, and corn stover. After 72 h of hydrolysis, the maximum reducing sugars yield was 5.16 mg/mL for BSG and 4.94 mg/mL for corn stover.
Enzymatic hydrolysis is a very important step in bioethanol production. Different enzymes are included in the degradation of lignocellulosic biomass. The main component of lignocellulose, cellulose, is often very recalcitrant to biodegradation to monomeric sugars. Literature survey showed that chemical pre-treatments of lignocellulosic substrates improve the digestibility of lignocellulosic material; and thus, the higher amount of reducing sugars could be released during hydrolysis [55]. Lu and coworkers [56] obtained higher reducing sugars yield than that in our study (0.42 g/g vs. 0.11 g/g (4.94 mg/mL) after hydrolysis using pretreated corn stover with dilute sulfuric acid, while 5.5 mg/mL of reducing sugars was obtained in the work of Li et al. [57] using alkali pretreatment of corn stover with additional homogenization. Also, in the case of BSG, some studies indicate that thermomechanical pretreatment at different pressure levels could increase hydrolysis yield [58]. Ravindran and coworkers [59] reported a lower yield of obtained reducing sugars using native BSG (79.67 mg/g BSG) as in our study 103.20 mg/g BSG (5.16 mg/mL), while acid and alkali-treated BSG had the highest reducing sugars yield (208.78 mg/g BSG and 228.25 mg/g BSG.) A similar trend was reported using corn stover as a substrate for hydrolysis. The yield of reducing sugars (13.65 g/L) was observed in Pleurotus sajor-caju pretreated corn stover samples after enzymatic hydrolysis of 60 h [35] which was higher than the obtained value in this study.
There is a lack of literature data concerning the application of the enzymatic potential of B. adusta in lignocellulosic hydrolysis. It should be noted that, for the first time, we showed that a crude enzyme cocktail, produced by B. adusta, could be involved in lignocellulosic hydrolysis. No pretreatment of lignocellulosic substrates was performed prior to hydrolysis, in order to evaluate the enzymatic potential of the member of Bjerkandera genus for lignocellulosic hydrolysis. Nevertheless, further experiments, with additional pretreatment of the lignocellulosic substrate, are necessary for more efficient hydrolysis, under the circular economy approach.
3.6 Bioethanol production
For ethanol production, previously obtained BSG and corn stover hydrolysates were used. After 48 h of fermentation by waste brewer’s yeast S. cerevisiae, the obtained ethanol concentrations were 0.94 g/L with fermentation efficiency of 35.72% for BSG and 0.86 g/L of ethanol with 34.13% of fermentation efficiency for corn stover (Table 5).
Recently published studies about ethanol production using BSG showed higher values of obtained ethanol concentration (from 8.3 to 17.3 g/L) [60,61,62,63] than in this study (0.94 g/L). The main reason for lower ethanol concentration is the lower concentration of reducing sugars in the starter fermentation broth. Also, in these studies, the pre-treatment of BSG was done to remove lignin and to allow an easier way for enzyme attack and saccharification. In addition, in these studies, commercial enzymes were used for hydrolysis with higher activity than in-house produced enzymes in this study. The concentration of produced bioethanol could be higher if pentoses and hexoses, as reducing sugars, could be fermented by yeast or some other fermentative microorganism [64].
Similar was observed using corn stover as the substrate for hydrolysis. The higher bioethanol yield, than in our study, of 57.8% was obtained from the corn stover pretreated with white-rot fungi Ceriporiopsis subvermispora after 35 days of treatment, while untreated corn stover showed lower ethanol yield compared to our study (15.90% vs. 35.72%) [65]. On the other hand, in the study of Ding and coworkers [35], lower ethanol yields were reported (0.096 g/g, 0.076 g/g, and 0.124 g/g of BSG vs. 0.414 g/g BSG) using white-rot fungi Coriolopsis gallica, Trametes versicolor, and Pleurotus sajor-caju for corn stover pretreatment, respectively.
Nevertheless, it should be noted that in this study we showed for the first time that crude enzyme mix produced by a novel isolate B. adusta TMF1 could be used for lignocellulosic hydrolysis and ethanol production. Although the obtained results are lower than in most published studies, application of pre-treatment and optimization of the hydrolysis process, as well as yeast fermentation, should be considered and performed in the following period.
4 Conclusions
In this study, the enzymatic potential of three newly isolated WRF strains was examined during the growth on different agricultural waste substrates. According to obtained results, SFM, SBM, SCR, and BSG were found to be potent substrates for the production of industrially important enzymes by tested fungal isolates. However, their potency varied in the induction of specific enzymes, mainly caused by substrates’ composition, but was also strain dependent.
The newly isolated F. fomentarius TMF2 was able to grow and produce various hydrolases and laccases with maximum activities obtained on SFM. The BSG was a very potent substrate for amylase and pectinase production by B. adusta TMF1 and S. commune TMF3, while on SBM maximum of pectinase activity for B. adusta TMF1 was reported. The SCR were the least potent substrate for all tested white-rot fungi isolates.
Both obtained hydrolysates, BSG and corn stover, were used for bioethanol production. Although the ethanol yield is relatively low, this study indicates that the crude enzyme cocktail produced by novel WRF isolate B. adusta TMF1 has potential for hydrolysis of lignocellulosic materials in bioethanol production.
Data Availability
Not applicable.
Code availability
Not applicable.
Abbreviations
- ANOVA:
-
Analysis of variance
- BSG:
-
Brewerʼs spent grain
- CMC:
-
Carboxymethyl cellulose
- CTAB:
-
Cetyl trimethyl ammonium bromide
- DNA:
-
Deoxyribonucleic acid
- DNS method:
-
Dinitrosalicylic acid method
- ITS:
-
Internal transcribed spacer
- MEA:
-
Malt extract agar
- NCBI:
-
The National Center for Biotechnology Information
- PCR:
-
Polymerase chain reaction
- rRNA:
-
Ribosomal ribonucleic acid
- SBM:
-
Soybean meal
- SCR:
-
Spent coffee residues
- SFM:
-
Sunflower meal
- SSF:
-
Solid-state fermentation
- WRF:
-
White-rot fungi
References
Serbent MP, Guimarães DKS, Drechsler-Santos ER, Helm CV, Giongo A, Tavares LBB (2020) Growth, enzymatic production and morphology of the white-rot fungi Lentinuscrinitus (L.) Fr. upon 2,4-D herbicide exposition. Int J Environ Sci Technol 17(5):2995–3012. https://doi.org/10.1007/s13762-020-02693-1
Rytioja J, Hildén K, Yuzon J, Hatakka A, de Vries RP, Mäkelä MR (2014) Plant-polysaccharide-degrading enzymes from Basidiomycetes. Microbiol Mol Biol Rev 78(4):614–649. https://doi.org/10.1128/MMBR.00035-14
Elisashvili V, Kachlishvili E, Tsiklauri N, Metreveli E, Khardziani T, Agathos SN (2009) Lignocellulose-degrading enzyme production by white-rot Basidiomycetes isolated from the forests of Georgia. World J Microbiol Biotechnol 25(2):331–339. https://doi.org/10.1007/s11274-008-9897-x
Jo WS, Park HN, Cho DH, Yoo YB, Park SC (2011) Detection of extracellular enzyme activities in Ganoderma neo-japonicum. Mycobiology 39(2):118–120. https://doi.org/10.4489/MYCO.2011.39.2.118
Ijoma GN, Tekere M (2017) Potential microbial applications of co-cultures involving ligninolytic fungi in the bioremediation of recalcitrant xenobiotic compounds. Int J Environ Sci Technol 14(8):1787–1806. https://doi.org/10.1007/s13762-017-1269-3
Kobakhidze A, Asatiani M, Kachlishvili E, Elisashvili V (2016) Induction and catabolite repression of cellulase and xylanase synthesis in the selected white-rot basidiomycetes. Ann Agrar Sci 14(3):169–176. https://doi.org/10.1016/j.aasci.2016.07.001
Ahmadi Khozani M, Emtiazi G, Aghaei SS, Ghasemi SM, Zolfaghari MR. Application of fungal laccase for heavy metals precipitation using tannin as a natural mediator. Int J Environ Sci Technol. 2020;(0123456789). https://doi.org/10.1007/s13762-020-02992-7
Terrasan CRF, Carmona EC (2015) Solid-state fermentation of brewer’s spent grain for xylanolytic enzymes production by Penicilliumjanczewskii and analyses of the fermented substrate. Biosci J 31(6):1826–36. https://doi.org/10.14393/BJ-v31n6a2015-30044
Martinez-Carrera D, Aguilar A, Martinez W, Bonilla M, Morales P, Sobal M. Mushroom cultivation on coffee pulp. Commer Prod Mark Edible Mushrooms Cultiv Coffee Pulp Mex. 2018;471–88.
Lynch KM, Steffen EJ, Arendt EK (2016) Brewers’ spent grain: a review with an emphasis on food and health. J Inst Brew 122(4):553–568. https://doi.org/10.1002/jib.363
Lomascolo A, Uzan-Boukhris E, Sigoillot JC, Fine F (2012) Rapeseed and sunflower meal: a review on biotechnology status and challenges. Appl Microbiol Biotechnol 95(5):1105–1114. https://doi.org/10.1007/s00253-012-4250-6
Murthy PS, Madhava NM (2012) Sustainable management of coffee industry by-products and value addition - a review. Resour Conserv Recycl 66:45–58. https://doi.org/10.1016/j.resconrec.2012.06.005
Wang F, Terry N, Xu L, Zhao L, Ding Z, Ma H. 2019 Fungal laccase production from lignocellulosic agricultural wastes by solid-state fermentation: a review. Vol. 7, Microorganisms. MDPI AG; https://doi.org/10.3390/microorganisms7120665
Milić MD, Buntić AV, Mihajlovski KR, Ilić NV, Davidović SZ, Dimitrijević-Branković SI (2021) The development of a combined enzymatic and microbial fermentation as a viable technology for the spent coffee ground full utilization. Biomass Convers Biorefin. https://doi.org/10.1007/s13399-021-01605-8
Shah TA, Ullah R (2019) Pretreatment of wheat straw with ligninolytic fungi for increased biogas productivity. Int J Environ Sci Technol 16(11):7497–7508. https://doi.org/10.1007/s13762-019-02277-8
Różyło K, Bohacz J (2020) Microbial and enzyme analysis of soil after the agricultural utilization of biogas digestate and mineral mining waste. Int J Environ Sci Technol 17(2):1051–1062. https://doi.org/10.1007/s13762-019-02522-0
Zhu N, Liu J, Yang J, Lin Y, Yang Y, Ji L et al (2016) Comparative analysis of the secretomes of Schizophyllum commune and other wood-decay basidiomycetes during solid-state fermentation reveals its unique lignocellulose-degrading enzyme system. Biotechnol Biofuels 9(1):1–22. https://doi.org/10.1186/s13068-016-0461-x
Seifert KA, Rossman AY (2010) How to describe a new fungal species. IMA Fungus 1(2):109–116
Carrillo-Nieves D, Saldarriaga-Hernandez S, Gutiérrez-Soto G, Rostro-Alanis M, Hernández-Luna C, Alvarez AJ et al (2020) Biotransformation of agro-industrial waste to produce lignocellulolytic enzymes and bioethanol with a zero waste. Biomass Convers Biorefin. https://doi.org/10.1007/s13399-020-00738-6
Mihajlovski K, Radovanović Ž, Carević M, Dimitrijević-Branković S (2018) Valorization of damaged rice grains: optimization of bioethanol production by waste brewer’s yeast using an amylolytic potential from the Paenibacilluschitinolyticus CKS1. Fuel 224(March):591–599. https://doi.org/10.1016/j.fuel.2018.03.135
Nargotra P, Sharma V, Sharma S, Kapoor N, Bajaj BK (2020) Development of consolidated bioprocess for biofuel-ethanol production from ultrasound-assisted deep eutectic solvent pretreated Partheniumhysterophorus biomass. Biomass Convers Biorefin. https://doi.org/10.1007/s13399-020-01017-0
Bušić A, Mardetko N, Kundas S, Morzak G, Belskaya H, Šantek MI et al (2018) Bioethanol production from renewable raw materials and its separation and purification: a review. Food Technol Biotechnol 56(3):289–311. https://doi.org/10.17113/ftb.56.03.18.5546
Zhang YJ, Zhang S, Liu XZ, Wen HA, Wang M (2010) A simple method of genomic DNA extraction suitable for analysis of bulk fungal strains. Lett Appl Microbiol 51(1):114–118. https://doi.org/10.1111/j.1472-765X.2010.02867.x
Jović J, Buntić A, Radovanović N, Petrović B, Mojović L (2018) Lignin-degrading abilities of novel autochthonous fungal isolates Trameteshirsuta F13 and Stereumgausapatum F28. Food Technol. Biotechnol 56(3):354–365. https://doi.org/10.17113/ftb.56.03.18.5348
White TJ, Bruns T, Lee S, Taylor J. Amplification and direct se-quencing of fungal ribosomal RNA genes for phylogenetics. In: PCR – protocols and applications – a laboratory manual. Cambridge, MA, USA: Academic Press, Inc 1990. pp. 315- 22.
Kasana RC, Salwan R, Dhar H, Dutt S, Gulati A (2008) A rapid and easy method for the detection of microbial cellulases on agar plates using Gram’s iodine. Curr Microbiol 57(5):503–507. https://doi.org/10.1007/s00284-008-9276-8
Miller GL (1959) Use of dinitrosalicylic acid reagent for determination of reducing sugar. Anal Chem 31(3):426–428
Mihajlovski K, Buntić A, Milić M, Rajilić-Stojanović M, Dimitrijević-Branković S (2021) From agricultural waste to biofuel: enzymatic potential of a bacterial isolate Streptomyces fulvissimus CKS7 for bioethanol production. Waste Biomass Valori 12(1):165–174. https://doi.org/10.1007/s12649-020-00960-3
Rittenour WR, Ciaccio CE, Barnes CS, Kashon ML, Lemons AR, Beezhold DH et al (2014) Internal transcribed spacer rRNA gene sequencing analysis of fungal diversity in Kansas City indoor environments. Environ Sci Process Impacts 16(1):33–43. https://doi.org/10.1039/C3EM00441D
Jatt AN, Tunio SA, Memon SB, Qureshi AS, Bhutto MA. API-ZYM enzymatic profile of. 2018;50(3):977–81. https://doi.org/10.17582/journal.pjz/2018.50.3.977.981
Kavkler K, Gunde-Cimerman N, Zalar P, Demšar A (2015) Fungal contamination of textile objects preserved in Slovene museums and religious institutions. Int Biodeterior Biodegrad 97:51–59. https://doi.org/10.1016/j.ibiod.2014.09.020
Hadda M, Djamel C, Akila O (2015) Screening of extracellular enzyme activities of Ganoderma and Fomes species collected from northern east Algeria. Res J Pharm Biol Chem Sci 6(4):1455–1462
Pandey AK, Vishwakarma SK, Srivastava AK, Pandey VK, Agrawal S, Singh MP (2014) Production of ligninolytic enzymes by white rot fungi on lignocellulosic wastes using novel pretreatments. Cell Mol Biol 60(5):41–5. https://doi.org/10.14715/cmb/2014.60.5.8
Sandra M, Laura L (2015) Production of lignocellulolytic enzymes from three white-rot fungi by solid-state fermentation and mathematical modeling. African J Biotechnol 14(15):1304–1317. https://doi.org/10.5897/AJB2014.14331
Ding C, Wang X, Li M (2019) Evaluation of six white-rot fungal pretreatments on corn stover for the production of cellulolytic and ligninolytic enzymes, reducing sugars, and ethanol. Appl Microbiol Biotechnol 103(14):5641–5652. https://doi.org/10.3390/microorganisms7120665
Quiroz-Castañeda RE, Balcázar-López E, Dantán-González E, Martinez A, Folch-Mallol J, Martínez-Anaya C. 2009 Characterization of cellulolytic activities of Bjerkandera adusta and Pycnoporus sanguineus on solid wheat straw medium. Electron J Biotechnol 12(4). https://doi.org/10.2225/vol12- issue4-fulltext-3
Papinutti VL, Diorio LA, Forchiassin F (2003) Production of laccase and manganese peroxidase by Fomessclerodermeus grown on wheat bran. J Ind Microbiol Biotechnol 30(3):157–160. https://doi.org/10.1007/s10295-003-0025-5
Kumar B, Bhardwaj N, Alam A, Agrawal K, Prasad H, Verma P (2018) Production, purification and characterization of an acid/alkali and thermo tolerant cellulase from Schizophyllum commune NAIMCC-F-03379 and its application in hydrolysis of lignocellulosic wastes. AMB Express 8(1):173. https://doi.org/10.1186/s13568-018-0696-y
Quiroz-Castañeda RE, Pérez-Mejía N, Martínez-Anaya C, Acosta-Urdapilleta L, Folch-Mallol J (2011) Evaluation of different lignocellulosic substrates for the production of cellulases and xylanases by the basidiomycete fungi Bjerkanderaadusta and Pycnoporussanguineus. Biodegradation 22(3):565–72. https://doi.org/10.1007/s10532-010-9428-y
Haq IU, Ashraf H, Iqbal J, Qadeer MA (2003) Production of alpha amylase by Bacillus licheniformis using an economical medium. Bioresour Technol 87(1):57–61
Rajoka MI, Huma T, Khalid AM, Latif F (2005) Kinetics of enhanced substrate consumption and endo-β-xylanase production by a mutant derivative of Humicolalanuginosa in solid-state fermentation. World J Microbiol Biotechnol 21(6–7):869–876. https://doi.org/10.1007/s11274-004-6030-7
Erdem E, Ucar MC, Kaymaz Y, Pazarlioglu NK (2009) New and different lignocellulosic materials from Turkey for laccase and manganese peroxidase production by Trametes versicolor. Eng Life Sci 9(1):60–65. https://doi.org/10.1002/elsc.200700025
Fan L, Pandey A, Mohan R, Soccol CR (2000) Use of various coffee industry residues for the cultivation of Pleurotusostreatus in solid state fermentation. Acta Biotechnol 20(1):41–52. https://doi.org/10.1002/abio.370200108
Tripathi A, Upadhyay RC, Singh S (2012) Extracellular ligninolytic enzymes in Bjerkanderaadusta and Lentinussquarrosulus. Indian J Microbiol 52(3):381–387. https://doi.org/10.1007/s12088-011-0232-0
Belcarz A, Ginalska G, Kornillowicz-Kowalska T (2005) Extracellular enzyme activities of Bjerkanderaadusta R59 soil strain, capable of daunomycin and humic acids degradation. Appl Microbiol Biotechnol 68(5):686–694. https://doi.org/10.1007/s00253-005-1918-1
Kaal EEJ, Field JA, Joyce TW (1995) Increasing ligninolytic enzyme activities in several white-rot Basidiomycetes by nitrogen-sufficient media. Bioresour Technol 53(2):133–139. https://doi.org/10.1016/0960-8524(95)00066-N
Agamuthu, P,A. Nithiya: Waste to enzymes through solid state fermentation. ISWA/APESB World Congress, 12–15 Okt 2009, Lisbon, Portugal. (2009).
Irshad M, Asgher M (2011) Production and optimization of ligninolytic enzymes by white rot fungus Schizophyllum commune IBL-06 in solid state medium banana stalks. African J Biotechnol 10(79):18234–18242. https://doi.org/10.5897/AJB11.2242
Shimazaki M, Matsuki T, Yamauchi K, Iwata M, Takahashi H, Sakamoto K et al (2008) Clinical performance of a salivary amylase activity monitor during hemodialysis treatment. Biomark Insights 2008(3):429–434
Babu CR, Harsha K, Sheik KB, Viswanatha CK (2018) Wheat bran-composition and nutritional quality: a review. Adv Biotechnol Microbiol 9(1):1–7. https://doi.org/10.19080/AIBM.2018.09.555754
Malathi V, Devegowda G (2001) In vitro evaluation of nonstarch polysaccharide digestibility of feed ingredients by enzymes. Poult Sci 80(3):302–305. https://doi.org/10.1093/ps/80.3.302
Ganbarov KG, Kulieva NA, Muradov PZ (2001) Biosynthesis of pectinase by fungi of the genera Bjerkandera and Coriolus during solid-phase fermentation. Appl Biochem Microbiol 37(6):593–595. https://doi.org/10.1023/A:1012303101102
Mehmood T, Saman T, Irfan M, Anwar F, Ikram MS, Tabassam Q (2019) Pectinase production from Schizophyllum commune through central composite design using citrus waste and its immobilization for industrial exploitation. Waste Biomass Valori 10(9):2527–2536. https://doi.org/10.1007/s12649-018-0279-9
Gautam A, Kumar A, Bharti AK, Dutt D (2018) Rice straw fermentation by Schizophyllum commune ARC-11 to produce high level of xylanase for its application in pre-bleaching. J Genet Eng Biotechnol 16(2):693–701. https://doi.org/10.1016/j.jgeb.2018.02.006
Barzee TJ, El- Mashad HM, Zhang R, Pan Z. Carrots. 2019 Integrated processing technologies for food and agricultural by-products. Elsevier Inc. 297–330. https://doi.org/10.1016/B978-0-12-814138-0.00012-5
Lu XB, Zhang YM, Yang J, Liang Y (2007) Enzymatic hydrolysis of corn stover after pretreatment with dilute sulfuric acid. Chem Eng Technol 30(7):938–944. https://doi.org/10.1002/ceat.200700035
Li Y, Ruan R, Chen PL, Liu Z, Pan X, Lin X et al (2004) Enzymatic hydrolysis of corn stover pretreated by combined dilute alkaline treatment and homogenization. Trans Am Soc Agric Eng 47(3):821–5. https://doi.org/10.13031/2013.16078
Rochelle L, Sciences P, Curie BM, Crépeau AM, Rochelle L. 2008 A thermomechanical process for improving enzymatic hydrolysis of brewer ’ s spent grain
Ravindran R, Jaiswal S, Abu-Ghannam N, Jaiswal AK (May 2018) A comparative analysis of pretreatment strategies on the properties and hydrolysis of brewers’ spent grain. Bioresour Technol 2018(248):272–279. https://doi.org/10.1016/j.biortech.2017.06.039
White JS, Yohannan BK, Walker GM (2008) Bioconversion of brewer’s spent grains to bioethanol. FEMS Yeast Res 8(7):1175–1184. https://doi.org/10.1111/j.1567-1364.2008.00390.x
Liguori R, Soccol CR, de Souza Vandenberghe LP, Woiciechowski AL, Faraco V (2015) Second generation ethanol production from brewers’ spent grain. Energies 8(4):2575–2586
Wilkinson S, Smart KA, Cook DJ (2014) Optimisation of alkaline reagent based chemical pre-treatment of Brewers spent grains for bioethanol production. Ind Crops Prod 62:219–227. https://doi.org/10.1016/j.indcrop.2014.08.036
Yohannan BK, White JS, Bennett J, Walker GM. Distiller’s spent grains: a substrate for bioethanol? Distill Spirits. 2012;(May):147–54.
Mahapatra S, Manian R (2020) Enhancement, production, and immobilization of beta-glucosidase from Zobellelladenitrificans VIT SB117 and its utilization in bioethanol production from lignocellulosic feedstock. Biomass Convers Biorefin. https://doi.org/10.1007/s13399-020-00718-w
Wan C, Li Y (2010) Microbial pretreatment of corn stover with Ceriporiopsissubvermispora for enzymatic hydrolysis and ethanol production. Bioresour Technol 101(16):6398–6403. https://doi.org/10.1016/j.biortech.2010.03.070
Acknowledgements
The authors would like to thank agricultural cooperative “Mrkšićevi salaši” for obtaining corn waste.
Funding
This work was supported by the Ministry of Education, Science and Technological Development of the Republic of Serbia (Contract No. 451–03-68/2020–14/200135 and 451–03-9/2021–14/200287) and Bilateral Project Serbia/Croatia (337–00-205/2019–09/35) (2019–2021). Ministarstvo Prosvete,Nauke i Tehnološkog Razvoja,451–03-68/2020–14/200135,451–03-9/2021–14/200287,Bilateral Project Serbia/Croatia (337–00-205/2019–09/35) (2019–2021)
Author information
Authors and Affiliations
Contributions
N. Ilić: planning of study, investigations on isolation of fungi and determination of qualitative and quantitative enzymes activities, data analysis, results discussion, manuscript writing. S. Davidović: investigations, manuscript writing, performing statistics. M. Milić: investigations on fermentation processes, data analysis, results discussion, manuscript writing. M. Rajilić-Stojanović: molecular identification of fungal isolates, editing. Danijela Pecarski: investigations on fermentation processes. Mirela Ivančić-Šantek: investigations on bioethanol production. K. Mihajlovski: planning of study, investigations on bioethanol production, data analysis, results verification, manuscript writing. S. Dimitrijević-Branković: conceptualization, planning, and supervision.
Corresponding author
Ethics declarations
Ethical Approval
All authors agree with the contents of the manuscript and its submission to Biomass Conversion and Biorefinery. This research has not been published before and is not under consideration for publication anywhere.
Conflict of interest
The authors declare no competing interests.
Additional information
Publisher's note
Springer Nature remains neutral with regard to jurisdictional claims in published maps and institutional affiliations.
Rights and permissions
About this article
Cite this article
Ilić, N., Davidović, S., Milić, M. et al. Valorization of lignocellulosic wastes for extracellular enzyme production by novel Basidiomycetes: screening, hydrolysis, and bioethanol production. Biomass Conv. Bioref. 13, 17175–17186 (2023). https://doi.org/10.1007/s13399-021-02145-x
Received:
Revised:
Accepted:
Published:
Issue Date:
DOI: https://doi.org/10.1007/s13399-021-02145-x